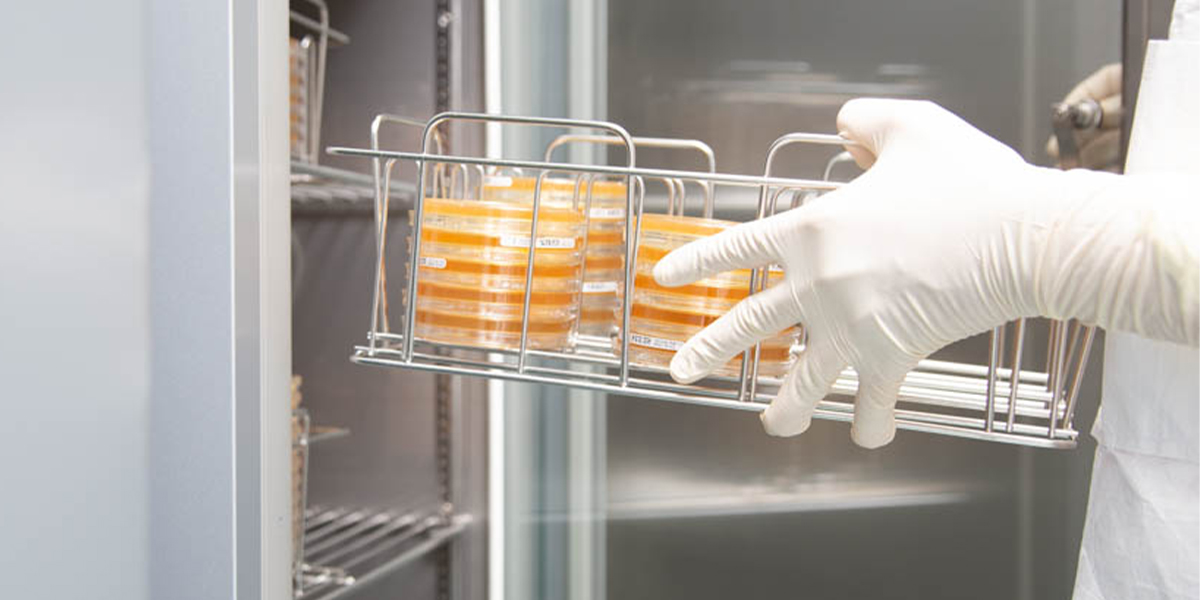
Trends Shaping the Future of Cell and Gene Therapy Manufacturing

4 min read
Trends Shaping the Future of Cell and Gene Therapy Manufacturing
AGC Biologics October 29, 2025 at 3:59 PM
As the industry matures and commercializes, the path forward will require close collaboration between therapy developers and manufacturing partners who can deliver not just capacity, but proven capability, regulatory expertise, and technological leadership
The cell and gene therapy (CGT) market is undergoing rapid change, backed by technological improvements, regulatory acceptance, and increasing demand with over 2,200 therapies currently in development worldwide and more than 60 gene therapies expected to receive approval by 2030. As programs advance from early research to late-stage and commercial development, the industry is being reshaped by evolving manufacturing strategies, technological breakthroughs, a need for standardized processes that are scalable, and shifting partnership models. Here we explore some of the trends and technologies shaping the future of this expanding market.
What Key Factors are Driving the Growth of Today’s Cell and Gene Market?
The CGT market is experiencing substantial growth, with projections indicating the market will exceed $70 billion globally over the next decade. Despite news of larger players like Galapagos, Novo Nordisk, and Takeda all pulling back on their programs in 2025, the projections show there is real promise. This expansion is being driven by maturing pipelines—expanding therapeutic indications beyond rare diseases into oncology, neurology, and chronic conditions—and an accelerating pace of regulatory approvals. Manufacturing demand has risen sharply to support a doubling of clinical trials since 2019, and the more than 10 new commercial products approved in recent years.
The CGT outsourcing market is also expanding rapidly to support this growing demand. As developers increasingly move their programs from early research phases into late-stage clinical trials and commercial production, the need for experienced manufacturing partners with proven regulatory track records has become critical. The scale of this pipeline growth—coupled with the technical complexity of CGT manufacturing—has positioned contract development and manufacturing organizations (CDMOs) as essential enablers of market expansion. Quite simply, if you don’t have a scalable process, you will not succeed. And today’s CDMOs are becoming a key player for helping developers achieve this goal and find success.
What Major Trends are Defining the Current Cell and Gene Competitive Environment?
Consolidation and Market Correction
The post-pandemic landscape has introduced significant structural changes to the CGT manufacturing sector. COVID-era investment fueled numerous GMP programs, but subsequent capital withdrawal led to program discontinuations and underutilized capacity across the industry. Likewise, early over-investment in adeno-associated viral vector (AAV) manufacturing has created more capacity than needed. Market corrections have forced some manufacturers to consolidate production into fewer, strategically located sites to improve operational efficiency and reduce costs. And even some developers with larger investments in their programs to abandon their pipeline altogether.
Global consolidation is being driven by multiple factors: the inherent complexity of CGT processes, ongoing capital constraints, the need for geographic diversification—especially across Asia—and geopolitical factors that are reshaping supply chain strategies. Continued mergers and acquisitions activity among CDMOs and biotech companies is expected, with larger players pursuing end-to-end capabilities while smaller innovators seek partnerships for access to innovative technology, manufacturing scale, and regulatory expertise.
Diversification and Differentiation
The competitive landscape is evolving through diversification and differentiation. Industry players are relying on integrated service offerings, proprietary technology platforms, and deep regulatory expertise to attract business. Capability—not just capacity—has emerged as the critical differentiator in this increasingly sophisticated market.
This extends to technological diversification as well, with multiple technology platforms continuing to coexist as developers strategically select approaches based on indication, therapeutic delivery route, and manufacturing feasibility.
Cell and gene therapy manufacturing platforms continue to become safer and more scalable. The industry is shifting away from older processes, exploring non-viral delivery methods such as lipid nanoparticles and CRISPR technologies, and accelerating the transition from autologous to allogeneic therapies. There is also growing interest in in vivo CAR-T and in vivo gene editing approaches that bypass complex ex vivo cell manipulation, potentially offering easier administration, lower cost, and greater scalability.
Overall, the market will remain competitive and increasingly industrialized through automation, with developers and manufacturers striving to utilize the latest technologies and innovative, scalable production processes to meet changing demands.
What New Technologies are Helping to Streamline and Decentralize Cell and Gene Therapy Production?
Technological innovation is playing a transformative role in advancing CGT manufacturing toward greater scalability, consistency, and cost-efficiency—all critical factors for broader patient access and commercial success. Specifically, the industry is shifting toward automated, digital, and decentralized manufacturing models to improve production speed, efficiency, quality, and global access.
Technological innovation is playing a transformative role in advancing CGT manufacturing toward greater scalability, consistency, and cost-efficiency
Automation is Driving Industrialization
Automated and closed manufacturing systems, particularly for autologous therapies, are transforming CGT from artisanal processes to industrialized platforms. Automation reduces manual steps, improves reproducibility, and lowers contamination risks across all manufacturing stages, increasing process scalability and cost-efficiency. This shift enables manufacturing decentralization, as repeatability can be achieved across multiple facilities using standardized automated processes and core technologies.
Digital Tools and AI are Alleviating Production Bottlenecks
The implementation of digital tools is streamlining production, alleviating quality control bottlenecks, and enhancing quality assurance processes. AI-driven process control, high-throughput solutions for remote QC testing using process analytical technologies, and real-time release testing capabilities are accelerating product release timelines while ensuring higher quality standards. Historically, quality control testing has been one of the largest bottlenecks in CGT manufacturing, and these innovations are directly addressing this challenge.
How has the role of the CDMO Evolved from a Service Provider to an “Innovation Partner”?
Within the CGT manufacturing sector, a strategic shift is underway from in-house development and manufacturing to outsourcing. High manufacturing costs and capital constraints have made CDMO outsourcing more attractive and scalable than building in-house facilities. Furthermore, developers increasingly seek end-to-end partners that can manage everything from process development and technology transfer to regulatory support and commercial manufacturing.
The role of the CDMO is also transforming from service provider to innovation partner as leading organizations invest in new capacity (infrastructure and equipment), develop new competencies to meet current market demands, and proactively anticipate future requirements for CGT developers. CDMO partnerships become the great equalizer for CGT developers—enabling smaller innovators to access the same advanced manufacturing capabilities and regulatory expertise as larger organizations.
Conclusion
The cell and gene therapy market is entering a transformative phase characterized by rapid growth, technological innovation, and strategic evolution. As the industry matures and commercializes, the path forward will require close collaboration between therapy developers and manufacturing partners who can deliver not just capacity, but proven capability, regulatory expertise, and technological leadership. The organizations that successfully navigate this dynamic landscape—embracing automation, digital tools, and strategic partnerships—will be best positioned to bring life-changing therapies to patients at scale.
_____________________________
Learn how you can partner with AGC Biologics to advance your CGT development and manufacturing projects to the next phase with confidence.



